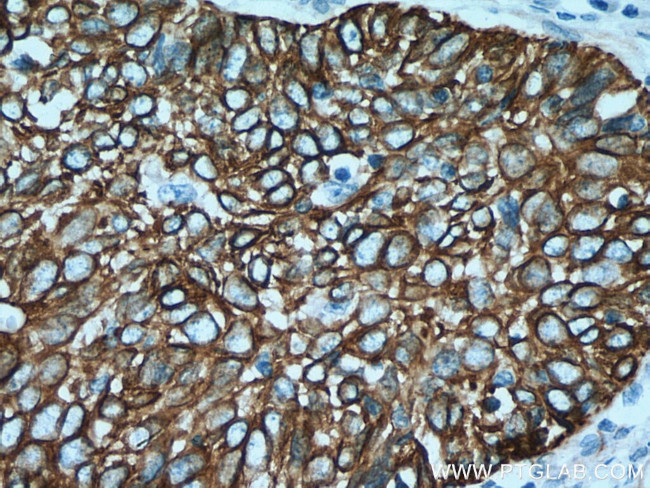
Cytokeratin 15 Antibody in Immunohistochemistry (Paraffin) (IHC (P))

Search
Proteintech
Cytokeratin 15 Polyclonal Antibody
{{$productOrderCtrl.translations['antibody.pdp.commerceCard.promotion.promotions']}}
{{$productOrderCtrl.translations['antibody.pdp.commerceCard.promotion.viewpromo']}}
{{$productOrderCtrl.translations['antibody.pdp.commerceCard.promotion.promocode']}}: {{promo.promoCode}} {{promo.promoTitle}} {{promo.promoDescription}}. {{$productOrderCtrl.translations['antibody.pdp.commerceCard.promotion.learnmore']}}
产品信息
10137-1-AP
种属反应
已发表种属
宿主/亚型
分类
类型
抗原
偶联物
形式
浓度
纯化类型
保存液
内含物
保存条件
运输条件
产品详细信息
Immunogen sequence: AYLKKNHEE EMKEFSSQLA GQVNVEMDAA PGVDLTRVLA EMREQYEAMA EKNRRDVEAW FFSKTEELNK EVASNTEMIQ TSKTEITDLR RTMQELEIEL QSQLSMKAGL ENSLAETECR YATQLQQIQG LIGGLEAQLS ELRCEMEAQN QEYKMLLDIK TRLEQEIATY RSLLEGQDAK MAGIGIREAS SGGGGSSSNF HINVEESVDG QVVS (238-450 aa encoded by B C002641)
靶标信息
Cytokeratin 15 is a member of the keratin gene family. The keratins are intermediate filament proteins responsible for the structural integrity of epithelial cells and are subdivided into cytokeratins and hair keratins. Most of the type I cytokeratins consist of acidic proteins which are arranged in pairs of heterotypic keratin chains and are clustered in a region on chromosome 17q21. 2.
仅用于科研。不用于诊断过程。未经明确授权不得转售。
生物信息学
蛋白别名: C K1CO; CK-15; cytokeratin 15; Cytokeratin-15; K15; keratin 15, type I; keratin complex 1, acidic, gene 15; Keratin, type I cytoskeletal 15; Keratin-15; keratin-15, basic; keratin-15, beta; KRT1; krt15 {ECO:0000250|UniProtKB:P19012}; type I cytoskeletal 15; Type I keratin Ka15
基因别名: AI528832; CK15; K15; K1CO; Ka15; Krt1-15; KRT15; KRTB
UniProt ID: (Human) P19012, (Mouse) Q61414, (Rat) Q6IFV3
Entrez Gene ID: (Human) 3866, (Mouse) 16665, (Rat) 287700